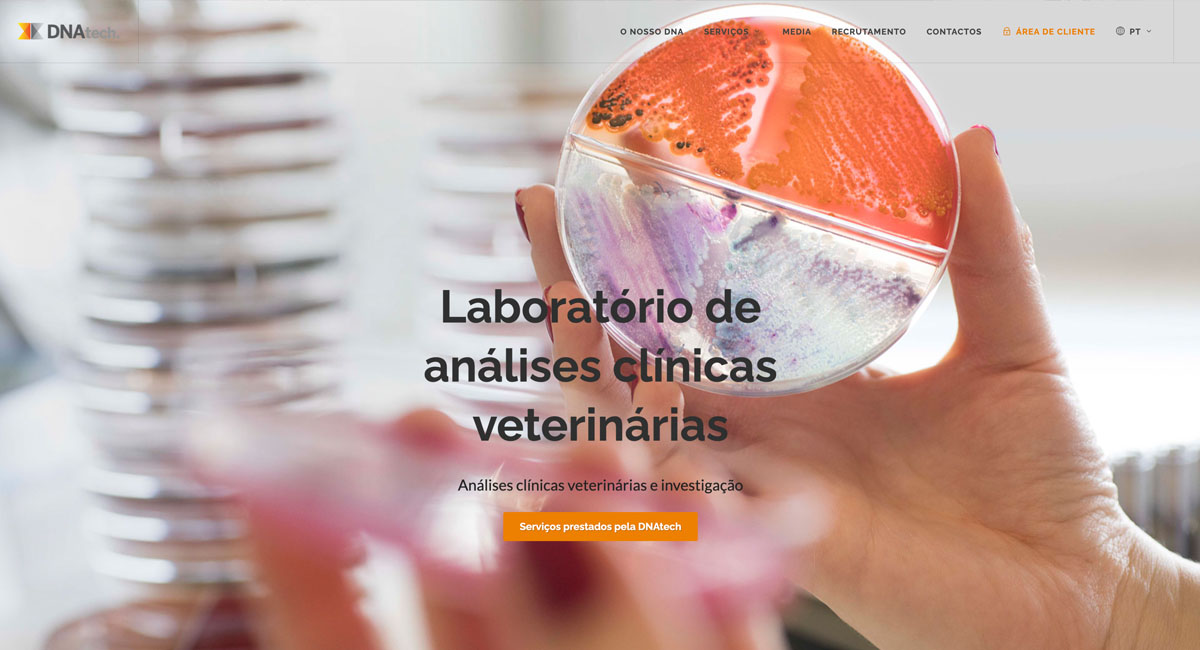
project-preview

Comunicação integrada e estratégica para a DNAtech
A colaboração entre a Webtexto e a DNAtech representa um exemplo sólido e bem-sucedido de comunicação estratégica integrada. Envolve, pois, múltiplas áreas de intervenção, essenciais para o fortalecimento da presença digital e da apresentação institucional do cliente.
Início da colaboração: 2017
Áreas de atuação: Website, Redes Sociais, Brochuras, Assessoria de Imprensa, Vídeo, Campanhas pagas
Visão geral e desafios
O desafio da DNAtech passava pela otimização e coordenação da comunicação em várias plataformas digitais e offline, assegurando coerência, consistência estética e impacto junto do público-alvo. A Webtexto desenvolveu uma abordagem estratégica abrangente para responder a estas necessidades.
Solução e resultados
-
Website institucional: desenvolvimento e gestão integral do website institucional da DNAtech, assegurando conteúdos otimizados, design atrativo e manutenção atualizada.
-
Redes sociais: gestão completa das redes sociais, incluindo planeamento estratégico dos temas, criação de copy e de imagens personalizadas, e publicação regular, aumentando significativamente o alcance e os índices de engagement da marca.
-
Brochuras corporativas: produção e design gráfico de brochuras informativas e de suportes de comunicação que reforçam eficazmente a apresentação institucional e comercial da DNAtech.
-
Assessoria de imprensa: implementação de uma estratégia proativa junto dos meios de comunicação, obtendo cobertura mediática relevante e consistente.
-
Vídeos: produção de vídeos dinâmicos e conteúdos audiovisuais adaptados às necessidades digitais e de marketing da marca.
-
Campanhas nas redes sociais: planeamento, criação e gestão de campanhas segmentadas e orientadas para resultados, nomeadamente para recrutamento.
Esta colaboração contínua resultou num aumento significativo da visibilidade da DNAtech, contribuindo para o robustecimento e a diferenciação da marca no seu setor.
Se procura um serviço de gestão de redes sociais com criatividade, consistência e profissionalismo, consulte a nossa equipa.
